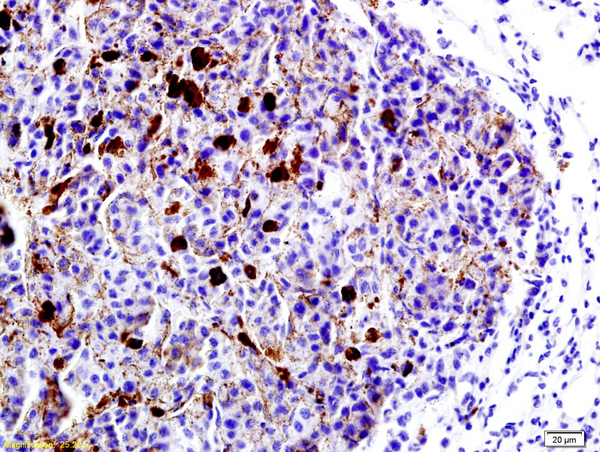

Formalin-fixed and paraffin embedded mouse brain labeled with Anti-LRP1/CD91 Polyclonal Antibody, Unconjugated (bs-2677R) at 1:200 followed by conjugation to the secondary antibody and DAB staining.
LRP1 Polyclonal Antibody
BS-2677R
ApplicationsFlow Cytometry, ImmunoFluorescence, ELISA, ImmunoCytoChemistry, ImmunoHistoChemistry, ImmunoHistoChemistry Frozen, ImmunoHistoChemistry Paraffin
Product group Antibodies
ReactivityBovine, Canine, Human, Mouse, Porcine, Rabbit, Rat, Sheep
TargetLRP1
Overview
- SupplierBioss
- Product NameLRP1 Polyclonal Antibody
- Delivery Days Customer16
- ApplicationsFlow Cytometry, ImmunoFluorescence, ELISA, ImmunoCytoChemistry, ImmunoHistoChemistry, ImmunoHistoChemistry Frozen, ImmunoHistoChemistry Paraffin
- Applications SupplierELISA(1:500-1000), FCM(1:20-100), IHC-P(1:200-400), IHC-F(1:100-500), IF(IHC-P)(1:50-200), IF(IHC-F)(1:50-200), IF(ICC)(1:50-200)
- CertificationResearch Use Only
- ClonalityPolyclonal
- Concentration1 ug/ul
- ConjugateUnconjugated
- Gene ID4035
- Target nameLRP1
- Target descriptionLDL receptor related protein 1
- Target synonymsA2MR, APOER, APR, CD91, DDH3, IGFBP-3R, IGFBP3R, IGFBP3R1, KPA, LRP, LRP1A, TGFBR5, prolow-density lipoprotein receptor-related protein 1, TbetaR-V/LRP-1/IGFBP-3 receptor, alpha-2-macroglobulin receptor, apolipoprotein E receptor, low density lipoprotein receptor-related protein 1, type V tgf-beta receptor
- HostRabbit
- IsotypeIgG
- Protein IDQ07954
- Protein NameProlow-density lipoprotein receptor-related protein 1
- ReactivityBovine, Canine, Human, Mouse, Porcine, Rabbit, Rat, Sheep
- Storage Instruction-20°C
- UNSPSC41116161
References
- Specific renal parenchymal-derived urinary extracellular vesicles identify age-associated structural changes in living donor kidneys. Turco AE et al., 2016, J Extracell VesiclesRead this paper